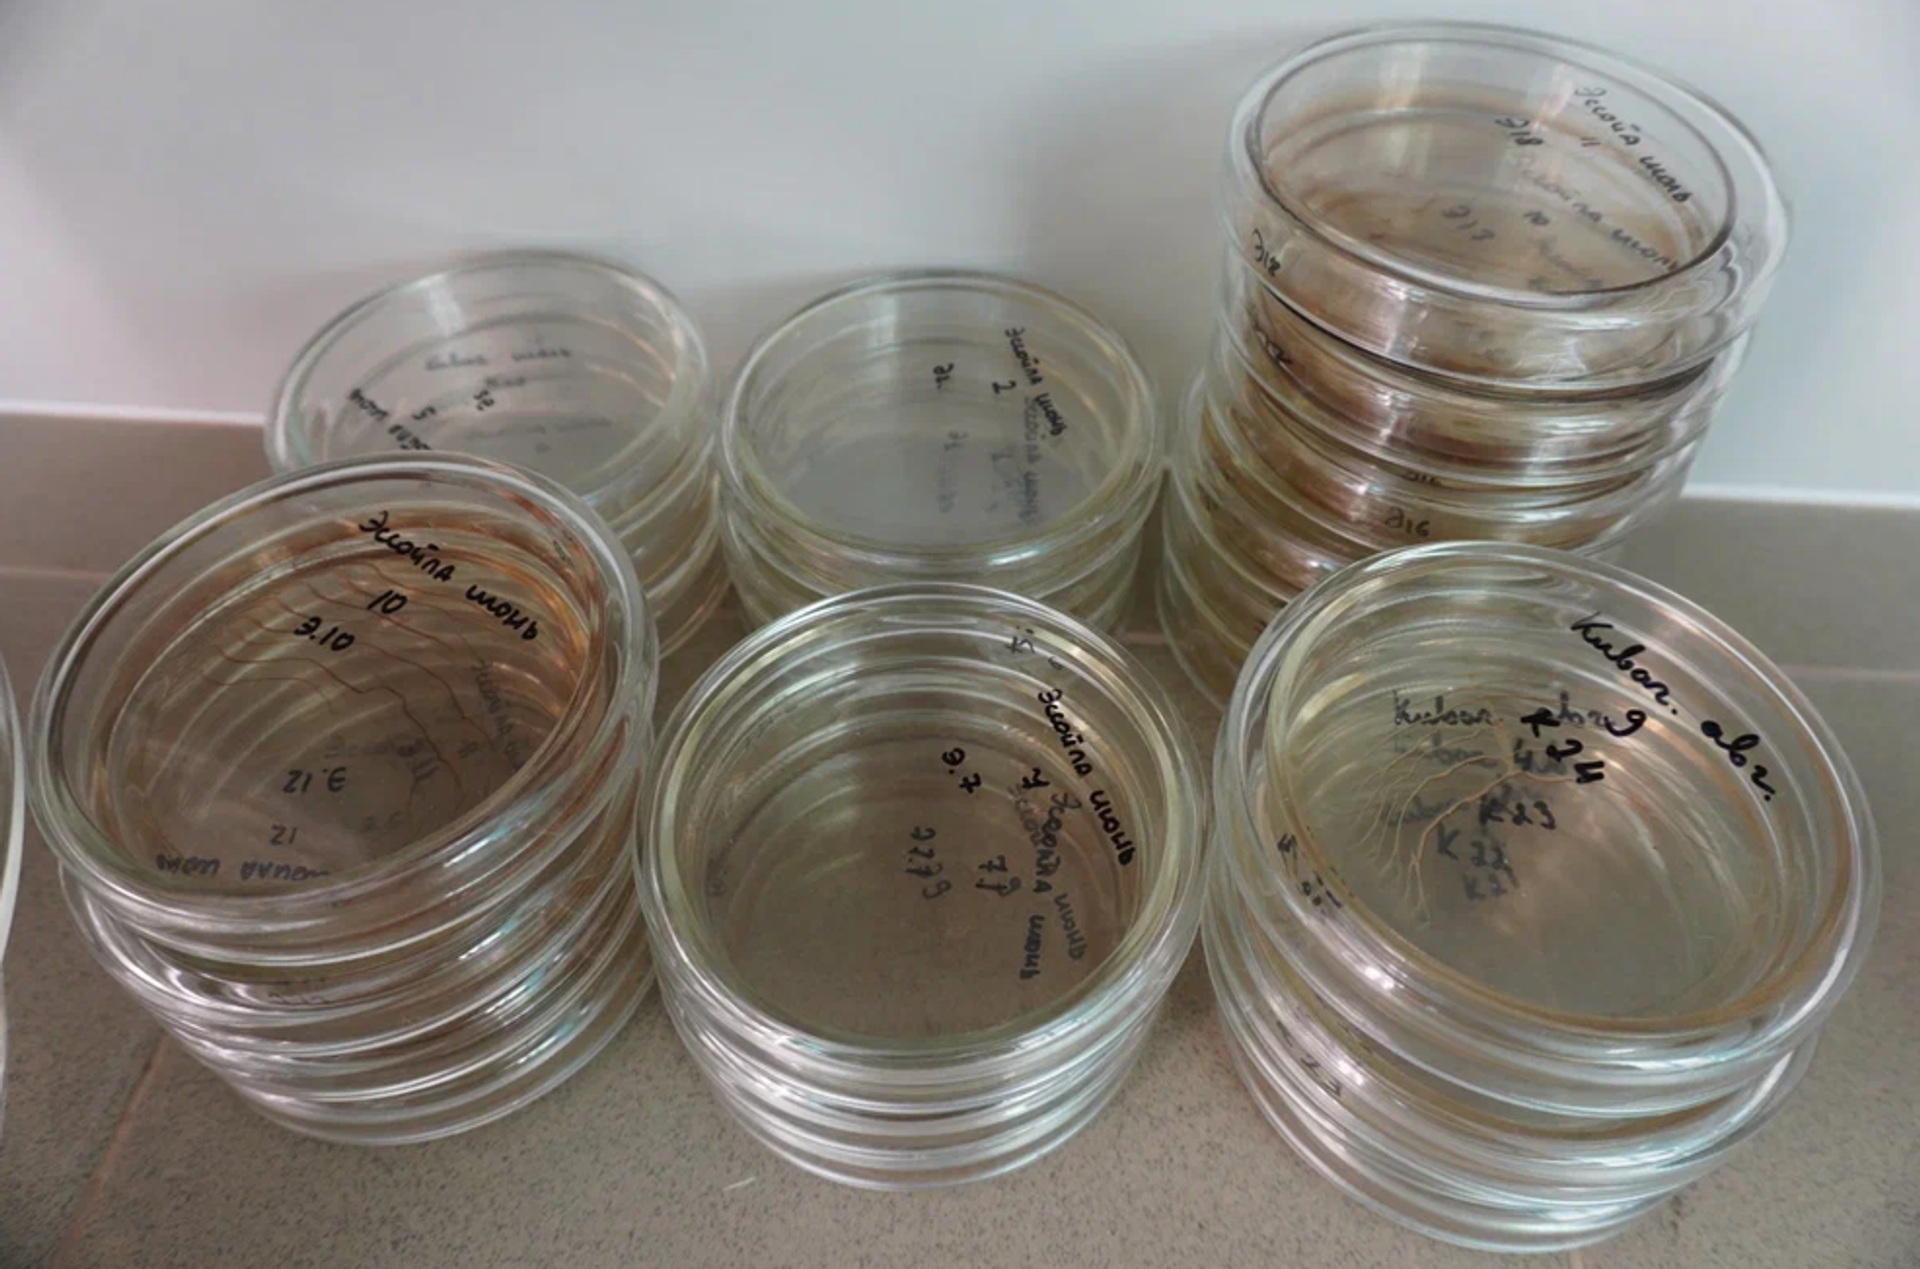
Muestras de algunos pantanos de Rusia Muestras de algunos pantanos de Rusia - Sputnik Mundo, 1920, 12.01.2025

Los estudios de pantanos: ¿cuán delicado es el equilibrio que se esconde bajo sus aguas?

© Foto : Nauchnaya Rossiya / Alexandr Kozlov
Síguenos en
Los pantanos absorben dióxido de carbono, pero también liberan metano, uno de los gases de efecto invernadero más potentes. En una entrevista con el portal 'Nauchnaya Rossiya' ('Rusia científica'), la candidata a Ciencias Químicas, Elizaveta Linkévich, explica por qué es importante estudiar los pantanos y qué han descubierto los científicos.
"Los pantanos son principalmente sumideros de carbono debido, en particular, a su elevado régimen hidrodinámico. La capacidad de absorción de los pantanos es más significativa porque la reserva de carbono almacenada en ellos es varias veces superior a sus tasas de emisión. No obstante, la cuestión sigue siendo polémica", aclara la analista.
Sin embargo, el delicado equilibrio depende en gran medida del cambio climático, advierte Linkévich.
"El calentamiento climático y las alteraciones hidrodinámicas podrían tener un fuerte impacto en el aumento de las emisiones de gases de efecto invernadero", continúa.
Muestras de algunos pantanos de Rusia
© Foto : Nauchnaya Rossiya / Alexandr Kozlov
En tal caso, en el pantano cambian la vegetación y los tipos de bacterias que viven en la turba, el microclima, la temperatura del suelo, así como el nivel de las aguas subterráneas, alerta.
"El estudio de los fenómenos multifactoriales de formación de gases de efecto invernadero en los pantanos se convierte en la tarea más importante del proceso de vigilancia, cuyo objetivo es acumular datos e identificar los factores relevantes e insignificantes para seguir buscando formas de regular el proceso", expresa.
Las investigaciones de los pantanos de Carelia
Linkévich precisa que la república rusa de Carelia fue una de las primeras regiones del noroeste de Rusia donde los investigadores empezaron a medir los gases de efecto invernadero en la superficie de los ecosistemas de pantanos en la década de 1990.
"Utilizando modernos equipos de campo, reanudamos estos estudios y mejoramos nuestro enfoque para estimar las emisiones de gases de efecto invernadero. (...) Ahora puedo concluir que allí donde los pantanos se calientan más, la emisión de gases de efecto invernadero será más intensa", subraya la analista.
El verano de 2024 fue anormalmente caluroso en Carelia, se batieron muchos récords de temperatura. Una de las áreas de investigación de la científica es analizar el impacto de este fenómeno en los gases de efecto invernadero.
"Hemos observado cierta correlación entre la sequedad del año en curso y el aumento de las emisiones de gases de efecto invernadero", destaca.

Laboratorio de estudios de pantanos
© Foto : Nauchnaya Rossiya / Alexandr Kozlov
En el año 2024, la cantidad de precipitaciones en la región fue inferior a la de 2023, y estos indicadores fueron especialmente bajos en agosto y septiembre, recuerda. La temperatura del aire atmosférico superó los valores normales en 2-3 °C en comparación con 2023, aclara la observadora.
"En estos meses, se registró un aumento de las emisiones de gases de efecto invernadero de casi el doble en comparación con 2023", indica.
De acuerdo con sus datos, los científicos observaron un calentamiento más profundo, de hasta 90 cm, del suelo y un descenso significativo del nivel freático.
"Descubrimos que el calentamiento del suelo, la disminución de las precipitaciones y el aumento de la exposición a la luz provocan un aumento de las tasas de emisión de dióxido de carbono en el pantano", enfatiza.
¿Con qué ayuda se realiza la investigación?
Para el estudio, Linkévich utiliza estaciones meteorológicas para el suelo con el fin de registrar el calentamiento del pantano a distintas profundidades y los cambios de humedad a lo largo de la estación de crecimiento.
"Planeamos identificar factores que regulen las emisiones de gases de efecto invernadero. Uno de esos factores es evaluar la actividad de los microorganismos que intervienen en la liberación de gases de efecto invernadero", comenta la analista.
Se trata de un campo de investigación muy interesante, comenta.
"Otro tema prometedor es el estudio de la estructura de los depósitos de turba, que aumentará los conocimientos sobre los procesos subyacentes de formación de emisiones de gases de efecto invernadero en combinación con la actividad de la microbiota de la turba", resume la científica.
En el futuro, Linkévich planea ampliar sus experimentos. Así, la analista con su equipo van a determinar la intensidad y el patrón de emisión de metano de los pantanos y relacionar esta emisión con el microclima del pantano.

No te pierdas las noticias más importantes
Suscríbete a nuestros canales de Telegram a través de estos enlaces.
Ya que la aplicación Sputnik está bloqueada en el extranjero, en este enlace puedes descargarla e instalarla en tu dispositivo móvil (¡solo para Android!).
También tenemos una cuenta en la red social rusa VK.

